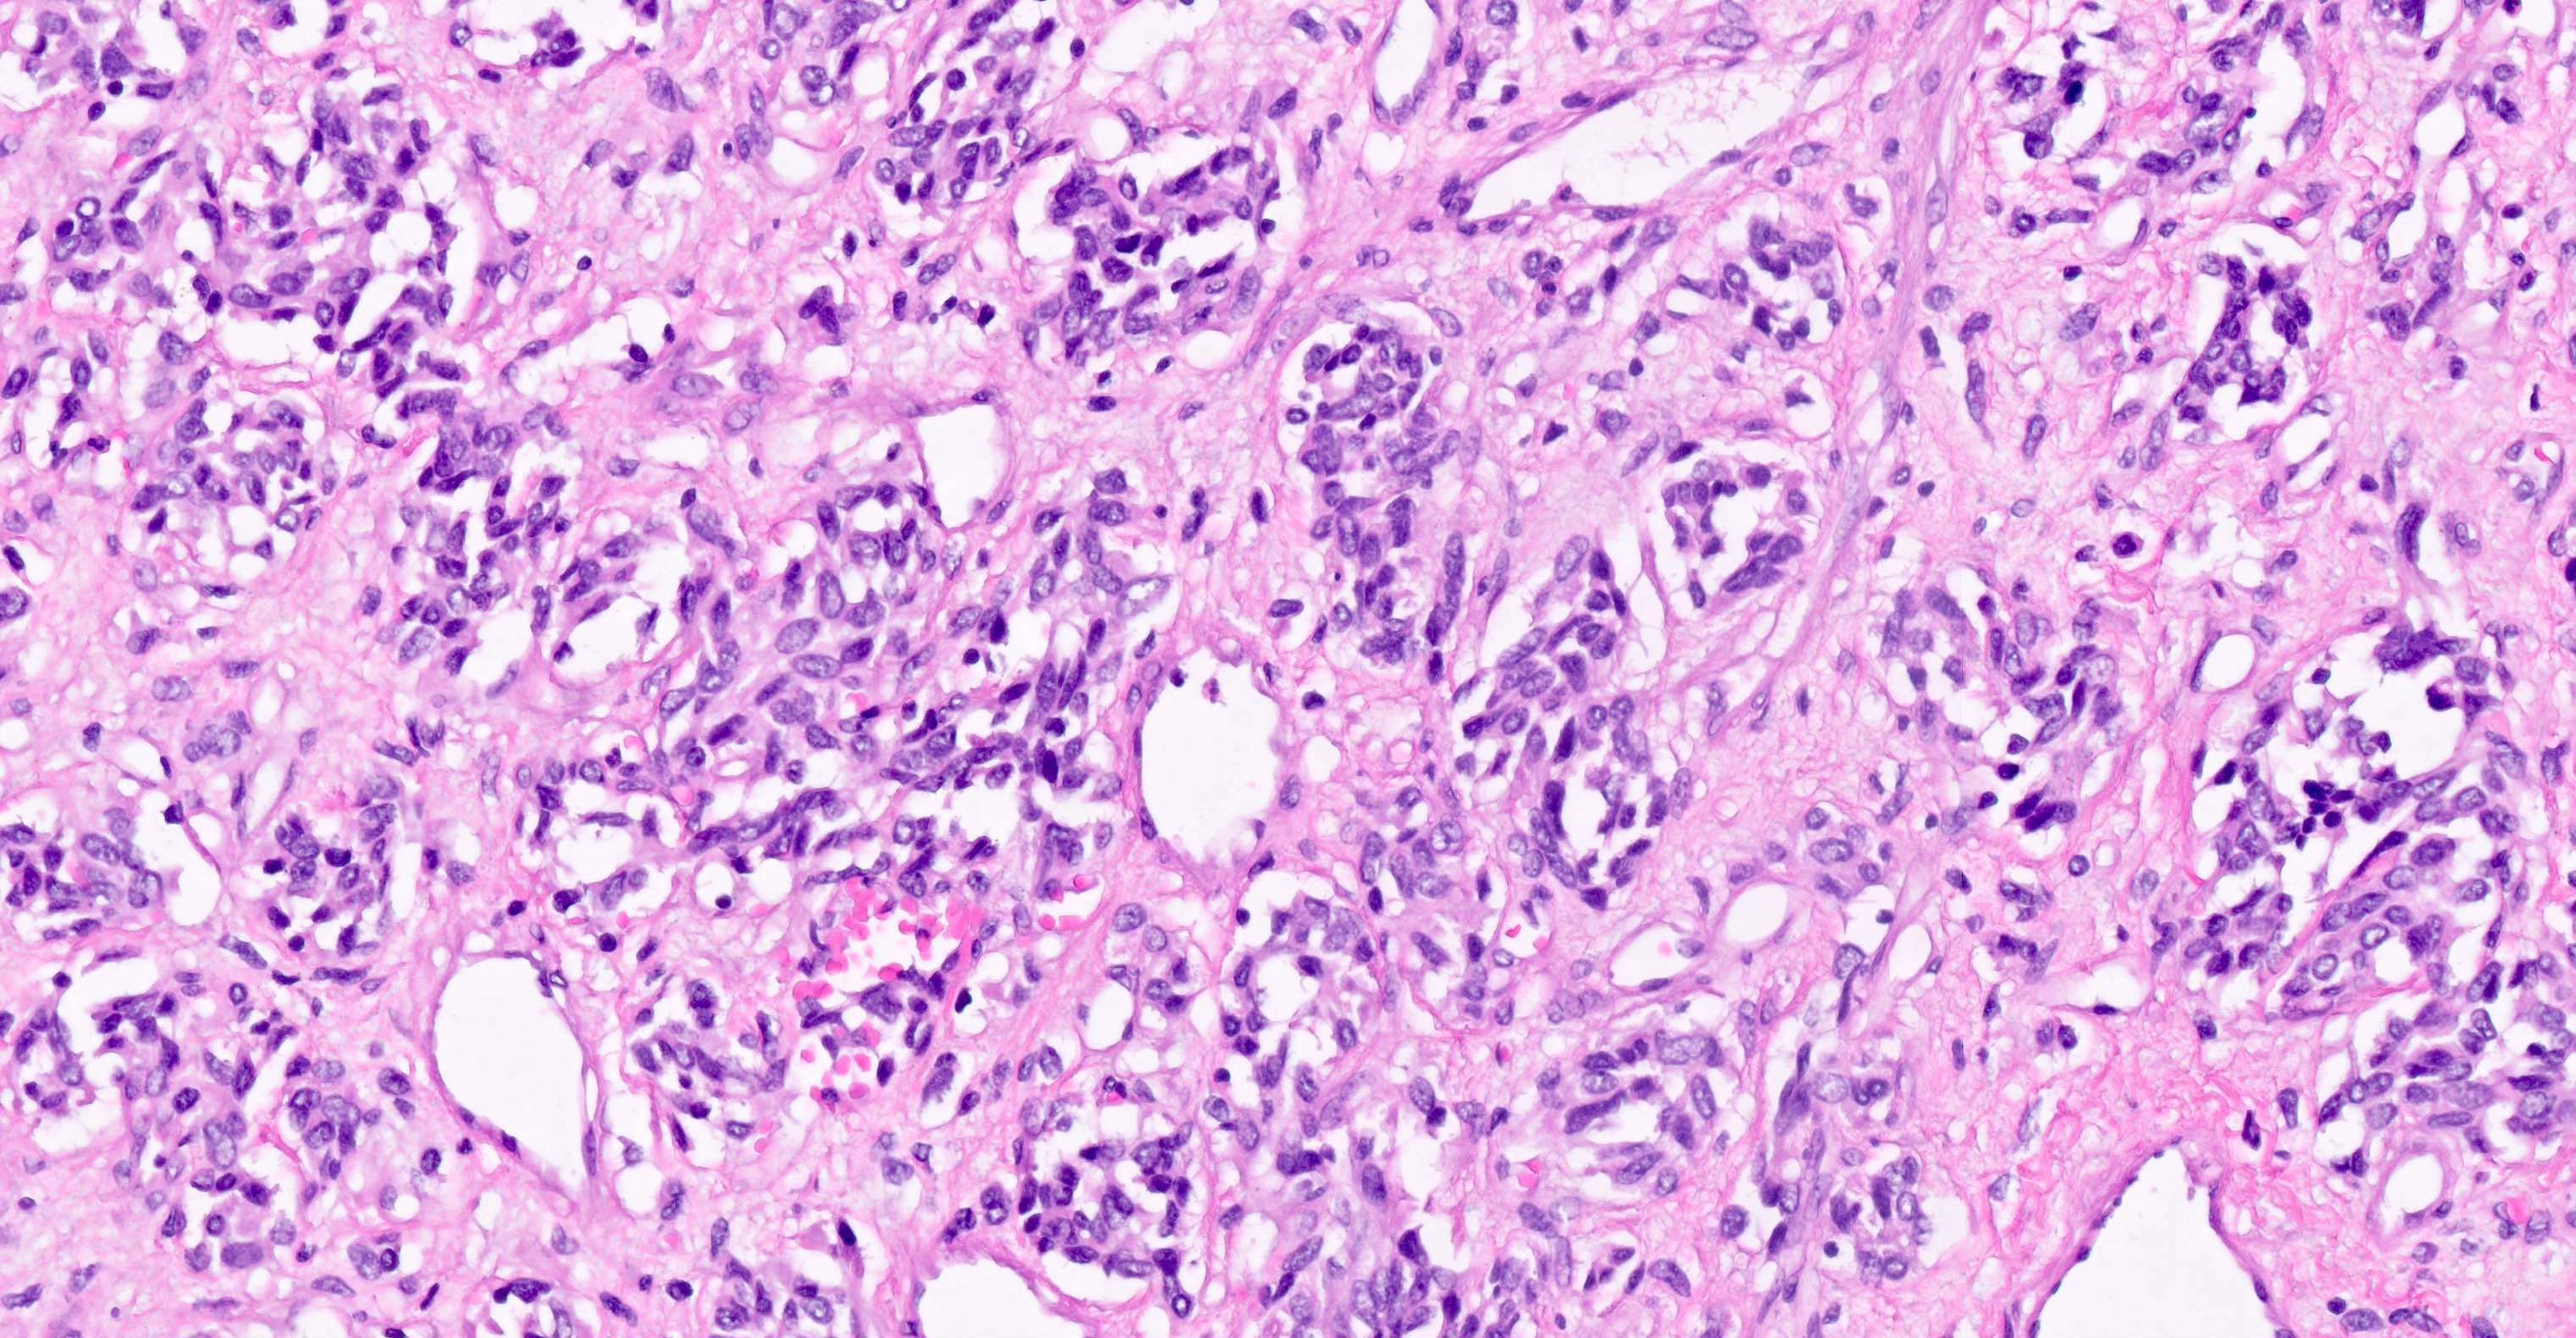

Table of Contents
Definition / general | Essential features | Pathophysiology | Clinical features | Interpretation | Uses by pathologists | Prognostic factors | Microscopic (histologic) images | Positive staining - normal | Positive staining - tumors | Negative staining - normal | Negative staining - tumors | Molecular / cytogenetics description | Board review style question #1 | Board review style answer #1Cite this page: Satgunaseelan L, Cheah AL. STAT6. PathologyOutlines.com website. https://www.pathologyoutlines.com/topic/stainsSTAT6.html. Accessed April 26th, 2024.
Definition / general
- Signal transducer and activator of transcription (STAT) 6
- Member of STAT transcription factor family
- In physiological state, cytokine stimulation and tyrosine phosphorylation of cytoplasmic STAT6 leads to transfer of STAT6 to nucleus for transcriptional roles in proliferation and immune regulation (Am J Clin Pathol 2015;143:672)
Essential features
- Highly sensitive (98 - 100%) and specific (100%) nuclear marker for solitary fibrous tumor at all anatomical locations, regardless of tumor morphology (Pathology 2014;46:389, Mod Pathol 2014;27:390, Am J Surg Pathol 2014;38:552)
Pathophysiology
- NAB2 (NGFI-A binding protein 2) represses transcription, while STAT6 influences gene expression by DNA promoter binding
- NAB2::STAT6 fusion results from an intrachromosomal inversion on 12q13 locus
- NAB2::STAT6 fusion gene acts as activator of EGR1 (early growth response 1) targeted transcription and relocates to the nucleus, with resultant strong nuclear expression of STAT6 by immunohistochemistry (Mod Pathol 2014;27:390, Am J Clin Pathol 2015;143:672)
Clinical features
- Some clinicopathological differences with NAB2::STAT6 fusion variants (Mod Pathol 2015;28:1324, Hum Pathol 2015;46:347)
Interpretation
- Nuclear stain
Uses by pathologists
- Distinction of solitary fibrous tumor (positive staining) from histological mimics (negative staining)
Prognostic factors
- No correlation between STAT6 expression and survival (Mod Pathol 2015;28:1324)
- No correlation between NAB2::STAT6 fusion variants and survival (Pathol Int 2016;66:288)
Microscopic (histologic) images
Positive staining - normal
- Differences in background positive staining may be influenced by antibody clone used (Pathology 2014;46:389, Am J Clin Pathol 2015;143:672)
- Scar (24%, nuclear and cytoplasmic) (Am J Clin Pathol 2015;143:672)
- Adipose tissue (8%) (Am J Clin Pathol 2015;143:672)
Positive staining - tumors
- Solitary fibrous tumor (98 - 100%), regardless of morphology or site, typically strong and diffuse (Pathology 2014;46:389, Pediatr Dev Pathol 2018;21:389, Acta Neuropathol 2013;125:651)
- Dedifferentiated liposarcoma (11 - 14%, reflects close proximity of MDM2 amplicon to STAT6 on chromosome 12q) (Mod Pathol 2014;27:1231, Mod Pathol 2014;27:390)
- Deep fibrous histiocytoma (10%, 1/10, weak) (Mod Pathol 2014;27:390)
Negative staining - normal
- Muscularis propria (Am J Clin Pathol 2015;143:672)
- Nerve (Am J Clin Pathol 2015;143:672)
- Myometrium (Am J Clin Pathol 2015;143:672)
Negative staining - tumors
- Undifferentiated pleomorphic sarcoma (< 2%) (Histopathology 2014;65:613)
- Cellular angiofibroma (Pathology 2014;46:389)
- Myofibroblastoma (Pathology 2014;46:389)
- Spindle cell lipoma (Pathology 2014;46:389)
- Benign fibrous histiocytoma (Pathology 2014;46:389)
- Schwannoma (Pathology 2014;46:389)
- Desmoid fibromatosis (Pathology 2014;46:389)
- Dermatosarcoma protuberans (Pathology 2014;46:389)
- Nodular fasciitis (Pathol Res Pract 2018;214:1544)
- Monophasic synovial sarcoma (Pathology 2014;46:389)
- Malignant peripheral nerve sheath tumor (Pathology 2014;46:389)
- Mesenchymal chondrosarcoma (Pathology 2014;46:389)
- Soft tissue angiofibroma (Genes Chromosomes Cancer 2017;56:750)
- Low grade fibromyxoid sarcoma (Am J Clin Pathol 2018;149:128)
- Superficial acral fibromyxoma (Hum Pathol 2017;60:192)
- Calcifying fibrous tumor of the pleura (Hum Pathol 2018;78:36)
- Phosphaturic mesenchymal tumor (Am J Surg Pathol 2017;41:1371)
- Myofibroma (Head Neck Pathol 2018;12:110)
- Leiomyoma (Pathol Res Pract 2018;214:1544)
- Dedifferentiated solitary fibrous tumor may show loss in dedifferentiated component (Int J Surg Pathol 2017;25:58)
Molecular / cytogenetics description
- RT-PCR and targeted next generation sequencing are the preferred methods of molecular diagnosis (Cancer Genet 2016;209:303)
- Cytogenetics / FISH studies may miss inversion breakpoints due to close proximity of NAB2 and STAT6 genes (Genes Chromosomes Cancer 2013;52:873)
- Common fusion variants include NAB2ex6-STAT6ex16/17 or NAB2ex4-STAT6ex2 (Pathol Int 2016;66:288)
Board review style question #1
Which of the following acts as the fusion partner for STAT6 in solitary fibrous tumor?
- EWSR1
- MDM2
- NAB2
- NCOA2
- NR4A3
Board review style answer #1
C. NAB2. NAB2::STAT6 fusion occurs secondary to an intrachromosomal inversion of the 12q13 locus, resulting in the fusion protein which relocates to the nucleus.
Comment Here
Reference: STAT6
Comment Here
Reference: STAT6